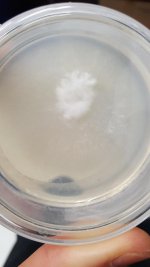
thumbnail.jpg

ThirdEyeDragonfly
I know nothing, I'm just sitting here looking at p
3 agar plates were inoculated 2.5 weeks ago, so far only one of the plates has growth. In the agar plate pictured, there's a white fluffy ball near the edge of the plate (initial inoculation point) and a strange, opaque, mycelium-like growth around it. It's colored differently and is surely not as dense as the fluffy white stuff, but still seems to be mushroom mycelium. The white ball showed up after one week of incubation and its growth has been steadily declining, however the opaque stuff around it has been proliferating since first signs of growth.
Is this plate healthy? Which part of this plate (opaque/white/both/or none) should be transferred to a fresh plate?

Is this plate healthy? Which part of this plate (opaque/white/both/or none) should be transferred to a fresh plate?